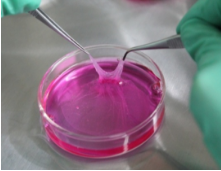
1532050051816004mtRd.png 圖片126.png

由歐洲藥品管理局(EMA)于2009年10月通過ATMP先進治療醫(yī)藥產(chǎn)品制度(2008年12月30日起,歐洲藥品管理局針對基因治療、干細胞治療、組織工程再生醫(yī)療的各種產(chǎn)品實行的一種制度)率先批準的細胞藥物——ChondroCelect。
ChondroCelect是由比利時著名生物制藥公司——TiGenix研發(fā)和生產(chǎn)的,這種藥物是一種先進的組織工程再生的醫(yī)療產(chǎn)品,主要用于治療膝骨關節(jié)炎,修復成人膝關節(jié)股骨髁的軟骨損傷。
膝骨關節(jié)炎大侵襲
全球目前約有4億人患有各種骨關節(jié)疾病,中國骨關節(jié)炎患者占其中的1/3,約有1.3億不同程度的骨關節(jié)炎患者飽受折磨,其中關節(jié)軟骨的損傷及炎癥是引起骨關節(jié)炎的主要原因。

被譽為“體壇尖兵”的冰上速滑名將葉喬波,作為1992年第16屆冬奧會獎牌“零”的突破第1人,她的頑強拼搏換來了寶貴的500米、1000米兩個項目的銀牌,由于她從小就進行滑冰動作的訓練及反復受傷,導致膝關節(jié)提前退化,20歲就得了創(chuàng)傷性關節(jié)炎,關節(jié)內(nèi)出現(xiàn)軟骨的碎片和游離體。帶著深深的遺憾,離開了她為之奮斗多年的冰壇,也無緣金牌。又如號稱“戰(zhàn)神”的藍球國手劉玉棟,膝關節(jié)軟骨損傷,雖經(jīng)過治療,重返戰(zhàn)場,但跑步時膝蓋無法靈活彎曲。
什么是膝關節(jié)軟骨損傷?

關節(jié)軟骨完好是關節(jié)行使正常功能的基礎,軟骨光滑而富有彈性,使關節(jié)能夠輕松自如的運動。但是,我們的關節(jié)軟骨會隨著年齡的增長而變薄,尤其是到20歲以后,軟骨內(nèi)的蛋白多糖濃度就開始逐漸下降,“凝膠”的粘彈性減低,潤滑的效果變差;并且,膠原纖維開始變粗易斷裂,軟骨的穩(wěn)定性變差;同時軟骨含水量也開始降低,物質(zhì)滲透減少,新基質(zhì)沉積速度變慢,軟骨的自我恢復能力也開始變差,這是時間給我們帶來的硬傷。
軟骨的彈性限度與負重的大小和受壓時間的長短息息相關。負荷越大,時間越長,軟骨受壓變形后回復的越不完全。比如,超負荷運動時間過長會讓軟骨持續(xù)受壓,過度的跑跳會讓軟骨瞬間壓力過大,長期跑步或走路的姿勢不正確也會給關節(jié)軟骨增加壓力,次數(shù)多了,關節(jié)軟骨間曲面吻合不良,就容易產(chǎn)生摩擦,加速退變,而運動損傷中就以關節(jié)軟骨損傷最為常見。

除了上述說運動帶來的損傷外,通過對大量的患者進行分析研究發(fā)現(xiàn)年齡、重復性創(chuàng)傷、遺傳因子、肥胖也會造成膝關節(jié)軟骨磨損,引發(fā)不同程度的骨關節(jié)炎病癥。
膝關節(jié)軟骨的磨損會有什么影響呢?
隨著時間的推移,這些不經(jīng)意間的磨損會讓軟骨越來越薄、關節(jié)表面變得凹凸不平,加速磨損。同時軟骨細胞也會失去原有的環(huán)境,使得細胞外基質(zhì)合成減少,自我修復能力降低。最后軟骨消失,關節(jié)骨端相對,就會形成骨性關節(jié)炎。不僅如此,長期的磨損或創(chuàng)傷后,軟骨細胞還會合成和釋放蛋白酶,反過來破壞自身軟骨。而軟骨被破壞后釋放的碎片,會進入滑液刺激滑膜,產(chǎn)生滑膜炎,進一步降解軟骨,加重軟骨損傷程度。
通常,膝關節(jié)軟骨損傷的患者感受是從最初的膝關節(jié)腫脹、疼痛,到行走困難、上樓下樓感到艱難,再到十分痛苦地站著難蹲下、蹲著站不起來,雖然此病進展緩慢,每個病人表現(xiàn)也不全相同,但最后轉(zhuǎn)歸都一樣——膝關節(jié)行走功能喪失。
ChondroCelect的誕生

ChondroCelect是由比利時TiGenix公司研發(fā)生產(chǎn)的,TiGenix公司的總部位于比利時魯汶。魯汶是比利時的一個非常古老的小城市,著名的魯汶大學(University of Leuven)就坐落于這座歷史悠久的城市,很多世界著名科學家如中國地質(zhì)學之父、近代石油工業(yè)之父翁文灝、1974年諾貝爾生理學或醫(yī)學獎得主克里斯汀·德迪夫、諾貝爾生理學或醫(yī)學獎得主阿爾伯特·克勞德、中國癌癥醫(yī)學家湯于翰等都曾在這所大學學習或研究過。

Dr. Frank P. Luyten和Dr.Gil Beyen于2000年在這座學術城市創(chuàng)立了TiGenix公司,這是一家專注于開發(fā)細胞的抗炎特性的先進的生物制藥公司,著重于開發(fā)用于嚴重醫(yī)療條件的新療法。
從2000年TiGenix剛成立開始,就開始基于ACI技術對ChondroCelect進行研究開發(fā),到2006年9月第三期臨床試驗結束,期間雖然經(jīng)歷了重重困難,但仍然在2007年6月1日向EMA提交申請,通過多次的聯(lián)合評估、多次技術探討,對毒性、致癌性等都做了檢測分析,最終于2009年10月通過了審批。
ChondroCelect如何作用于膝關節(jié)軟骨的磨損?
ChondroCelect是一種細胞懸液,大致的操作過程可以簡單表述為:通過經(jīng)手術從患者體內(nèi)取出一小片健康的軟骨,之后使用該公司的細胞濃縮技術對取出的正常軟骨進行培養(yǎng),期間過程需要大概3-4周的時間。當細胞經(jīng)檢測能具備確保產(chǎn)生出透明狀軟骨的時候,便要開始第二階段的手術,將培養(yǎng)的軟骨細胞與ChondroCelect細胞植入懸液再植入回患者受損關節(jié),讓軟骨細胞在那里附著于骨頭上并逐漸產(chǎn)生軟骨,但要注意的是在移植后需要用軟骨膜或者生物材料對植入細胞進行覆蓋。

通過這樣的方法可以為患者重新再生軟骨,再次活動自如,不再受關節(jié)疼痛的折磨。
審批的EMA是個什么組織?

ChondroCelect是由EMA審批上市的,那么這是個什么組織呢?有沒有足夠的資質(zhì)呢?那現(xiàn)在小編就給各位科普一下的!

EMA是歐洲藥品管理局European Medicines Agency的縮寫,歐洲藥品管理局的前身是歐洲藥物檢驗局(EMEA),在歐盟其地位相當于美國的食品藥品管理局(FDA)。目前EMA的辦公地址在英國倫敦,不過以后就不好說在哪了,為什么呢?隨著英國脫歐進程的繼續(xù),歐盟要將其從倫敦遷出,并由成員國自主申請,到7月31日截止,申請EMA的有19個國家,可謂是競爭激烈啊。
EMA的規(guī)模則十分龐大,擁有890名全職員工,其中大部分為各歐盟國家夢寐以求的高技術人才和專家。EMA主要負責管理整個歐盟市場上銷售的人類與動物健康藥物的藥品審批,其中包括目前全球的研究熱點——干細胞藥物也是由其負責審批上市的。除此以外,EMA日常還為本行業(yè)提供技術性指導,擁有頒發(fā)或吊銷藥品流通執(zhí)照的權力。EMA不僅權力巨大,同時商業(yè)價值也豐厚。每年EMA還會組織3600余名各國醫(yī)藥學專家研進行討會議,促進生物醫(yī)藥的安全發(fā)展。
雖然現(xiàn)在全球批準上市的干細胞藥物只有十幾種,公眾對干細胞療法的認知相對于傳統(tǒng)療法的認知也是相對匱乏的,這更讓干細胞產(chǎn)品的問世舉步維艱。但隨著各國對干細胞研究敞開大門,相信,越來越多治療嚴重疾病的干細胞療法、干細胞藥物會逐漸進入大眾視野,為人們了解和接受!